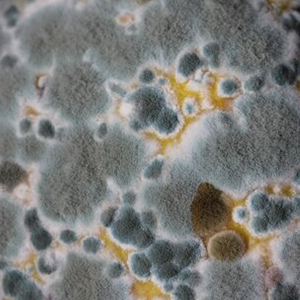

Decades of experienced service in grease traps, air and laundry duct cleaning, trash chutes, mold, lead, and asbestos abatement. IAQ investigations, sanitization and remediation for commercial, industrial, and institutional clients. NADCA certified.
Air Detoxification
Air Duct Cleaning
Cold Plasma
Commercial Laundry Exhaust
Trash Chute Services
General Workplace Indoor Air Quality
Mold Evaluation & Remediation
Lead Abatement
Deodorization & Dust Control
Anti-Microbial & Anti-Fungal Treatments
Sanitizing and Disinfection
Bio-Hazard Decontamination

-National Hospital Client